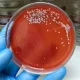
Nadużywanie antybiotyków powoduje coraz powszechniejszą lekooporność

Aktywne Wpisy

Hej, do końca tygodnia pracuje w większym januszeksie biurowym. Po oznajmieniu swojej decyzji o zmianie pracy większość się na mnie obraziła i skazała na ostracyzm "społeczny" na ostatnie dni mojej pracy. Mam wrażenie że w takich firmach większość załogi to ofiary syndromu sztokholmskiego. Proponowałem że dokończę swoje sprawy do końca miesiąca, ale szefowa się obraziła i kazała zawijać mandzur wcześniej. Chęć zarabiania więcej niż 4000 netto to jest obraża majestatu dla "królowej"

badej123 +307
źródło: IMG_20241120_034005
Pobierz

Wodoodporne lampki choinkowe w kształcie płatków śniegu zasilane trzema bateriami AA za $3,99 (~15,91PLN).
Dodając do koszyka łańcuch o długości 5m, kupimy go w cenie 2,5m (należy przejść do płatności).
Kolor: ciepły biały / różowy / RGB
Długość: 2,5m / 5m
Ilość płatków na łańcuchu: 20szt / 40szt
Zasilanie: 3 x AA
Link bez refa:
www.banggood.com/Christmas-Snowflake-Waterproof-Battery-LED-Flash-Lights-String-Decoration-Festival-Wedding-Landscape-p-1095561.htmlźródło: comment_HRX8SlO8VOxBm6MxeZak0olNjzayEZhb.jpg
PobierzKomentarz usunięty przez autora
Komentarz usunięty przez autora
Komentarz usunięty przez autora
Dopłaćcie 5zł więcej http://allegro.pl/lampki-28szt-led-kolorowe-platki-sniegu-li-11p-i6563183916.html
i kupcie na normalnym grubym kablu zielonym.
Silikon nie wytrzyma więcej niż 1 sezonu świecenia. Prędzej czy później będzie zwarcie i po lampkach.